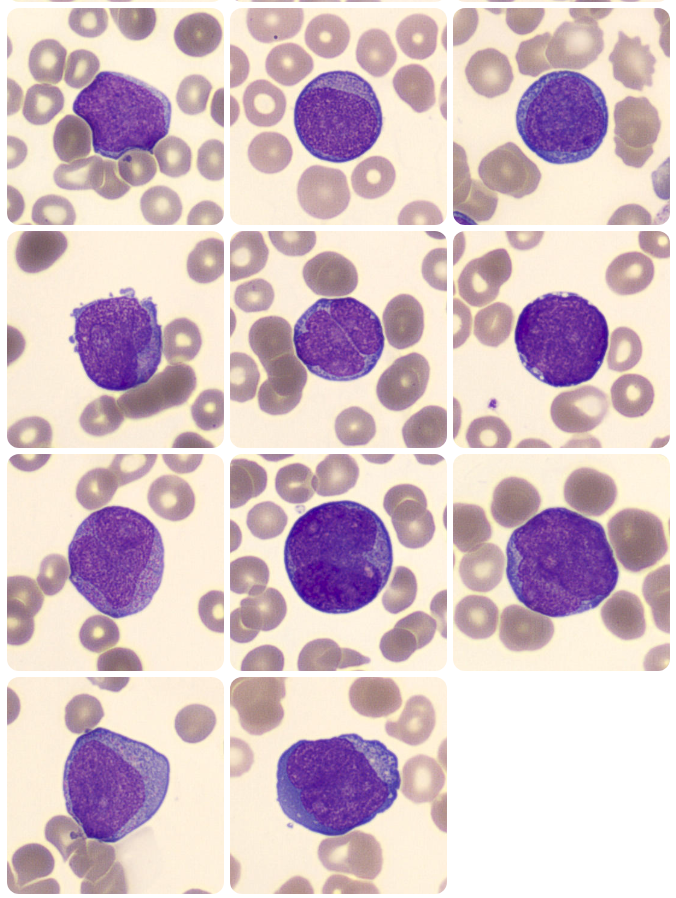

Blast cells are often feared by both newly qualified and highly experienced Biomedical Scientists alike. Although tricky, it is extremely important that anyone reviewing a peripheral smear is confident and capable of identifying them and taking the appropriate actions following identification. These cells are always pathological in the peripheral blood and it is vital for early intervention that this topic is afforded the time and patience it requires.
Blast cells are a hallmark feature of acute leukaemia and other serious bone marrow pathologies. Their unexpected presence in the peripheral blood can be the first indication of a life threatening condition and as such it is essential that BMS staff are able to recognise when these cells are present and ensure urgent escalation for diagnostic review.
When blast cells are present in a sample, they often fall outside of the normal maturation clusters used on the Sysmex XN analysers. These clusters help the scattergrams which can be found on the analysers themselves or are often displayed in whichever middleware your lab uses, like EIPU. Where a cell falls outside of the normal maturation cluster this means that the analyser cannot identify it accurately and results in the production of a blast flag. If you utilise the Sysmex analytical systems, the flags generated will be;
- Blasts/Abn Lympho?
- WBC Abnormal Scattergram
- IG Suspect
- Atypical Lymphocyte Suspect
These flags indicate that the automated differential is either incomplete or inaccurate and may contain immature or abnormal cells such as blasts. The analyser will not attempt to count blasts itself at any point, it will simply create a flag. In the event that these flags are present, a BMS should ensure that the sample is ran through an analyser with a WPC channel, such as the Sysmex XN20 analyser. This is because the WPC (White Precursor Cell) channel is designed for the enhanced detection of abnormal or immature cells. This Can assist in classifying blasts or atypical lymphocytes.
The WPC Channel uses fluorescent flow cytometry combined with its own lysis reagent (Lysercell WPC) and fluorescence reagent (Fluorocell WPC). The lysercell WPC lyses mature WBCs whilst preserving precursor cell, allowing the analyser to focus more specifically on detecting early stage or abnormal cells in the sample. Retained cells are analysed based on their nucleic acid content and cell structure. The resulting enhanced detected allows for the addition of a further flag;
- ?Blasts
This is generated where the analyser has determined that the cells in the sample have fallen outside of the normal gating regions and specifically into blast cell gating regions on the scattergram.
Blast cells are not normally present in peripheral circulation and their suspected presence will always warrant further investigation. Blasts are precursor cells found in the bone marrow which are responsible for the development of all mature cells. In healthy individuals the blasts make up ~5% of marrow cells. When seen in the peripheral blood, this is always atypical and can reflect uncontrolled cell proliferation, disruption of the bone marrow barrier, or overflow from regeneration/compensation in the bone marrow. These cells are undifferentiated and highly proliferative as well as being a key diagnostic feature of acute haematological malignancies. Early recognition is critical to initiating urgent escalation.
Morphological Identification of Blasts
Identifying blasts can often be tricky and the most important thing here is that you should seek further guidance from a fully DWCC trained member of staff in any circumstance where you are unsure. Blast cells are highly pleomorphic and this can make them difficult to identify however, there are a few key features that can be used to aid in their recognition.
There are different types of blasts, dependent upon the differentiation pathway which the blast is committed to. You will not be required to classify blasts, only recognise the features which would cause you to be suspicious that a cell may be a blast. With that said there are three main blasts that you may encounter; Myeloblasts, lymphoblasts, and monoblasts, all of which are named based upon their committed differentiation pathway.
- Cell Size – Blasts are typically larger than most mature WBCs, often 2-3x the size of a small lymphocyte.
- Nuclei – Nuclei are large and generally round or oval in shape and there is a large N:C ratio with the nucleus often taking up the majority of the cytoplasm.
- Chromatin – Fine, immature chromatin which appears smooth and delicate. Often described as ‘open’. This is because more immature cells require access to more of the genetic material within the nucleus to allow for cellular differentiation and proliferation. Chromatin may look as though it is composed of multiple fine dots rather than appearing as linear strands.
- Nuceoli – Contained within the nucleus, blast cells will often have one to three visible nucleoli.
- Auer Rods – These are only present in some cases however where present, this indicates that the blast is a myeloblast. Auer rods are thin, red/purple rod like inclusions in the cytoplasm.
It is important to know that no single feature identifies a blast. While many will show a combination of large size, fine chromatin, nucleoli, and pale blue cytoplasm some may show more subtle signs of immaturity. This may occur in mixed disease states or early stages of disease progression. This can make blast cell recognition inherently difficult, especially when abnormalities are borderline or give the impression of being reactive. Developing confidence in blast cell recognition takes time and effort. If you are unsure, always escalate your concerns to a DWCC trained member of staff. It is expected that you escalate where unsure, rather than assume a cell to be benign.
Blasts are categorised as myeloid, lymphoid, or monocytic by flow cytometry and not morphologically. Myeloid blasts are blast cells which show myeloperoxidase (MPO) positivity and will also express CD34, CD117, CD13, and CD33. Lymphoid blasts typically show CD19, CD10, CD22 and cyCD79a markers. Monoblasts will express MPO (as they are myeloid cells) however they express it more variably and so non specific esterase is also used for these cells as well as CD45. This is not an extensive list of flow cytometry markers and the interpretation of flow panels is incredibly complex and nuanced. I would encourage you to spend some time investigating it as supplementary information.
Below are a number of categorised examples of blast cells to assist in your learning and to be used as reference material.
Myeloblasts
Figure 1. Myeloblasts in the peripheral blood. (Adapted from https://www.cellwiki.net/en/cells/blasts-various, 2025)
Lymphoblasts

Figure 2. Lymphoblasts in the peripheral blood. (Adapted from https://www.cellwiki.net/en/cells/blasts-various, 2025)
Monoblasts

Figure 3. Monoblasts in the peripheral blood. (Adapted from https://www.cellwiki.net/en/cells/blasts-monocytic, 2025)
Preliminary Assessment of a Peripheral Blood Smear
Once a film has been produced and it has been determined that a scan for blast cells is required, this must be performed as promptly as possible to reduce delays in patient care where the recognition of blasts could contribute to early treatment of a pathology. Where blasts are considered to have been identified, 200 cell count needs to be performed to provide a high level of accuracy regarding the blast count before taking the film directly to a haematology consultant or registrar. The need for this increased accuracy is a direct result of the diagnostic criteria for acute leukaemia which states (at the time of writing in June 2025) that 20% blasts in the peripheral blood is a requirement.
- Scan the film with the x20 lens initially to get a feel for the overall picture and to determine the appropriate are of the film for inspection in greater detail. The area to examine will be the monolayer where cells are not overlapping but also not too far apart. This area can be generally be found around 2/3rds of the way across to slide, towards the feathered edge.
- Increase the magnification to the x40 lens and scan the film for the presence of cells displaying the characteristics of a blast. Please seek further guidance from a DWCC trained member of staff to assist with cell identification if you are unsure.
- Develop an overall impression of any suspicious cells within the film and ask yourself whether you believe that they may meet the criteria for being identified as a potential blast cell.
- If unable to identify cell types, remember that generally you are looking for large cells with a high N:C ratio, immature chromatin pattern, and visible nucleoli.
- Escalate or seek advice where you are unsure whether the cells are significant or the film shows unidentifiable cells.
- Please document your decision.
Final Thoughts
Recognition of blast cells in a peripheral film isn’t just about morphology training. It’s also about vigilance, clinical awareness, and the understanding of the weight that your observations can carry. Whilst automation plays a role in generating flags it is still the eye of a trained BMS that brings context and nuance to the results and makes the decision. By developing confidence in blast identification and knowing what steps to take we can uphold a high standard of diagnostic accuracy and contribute to early intervention where it is needed. The skill lies not only in what we see, but how we respond.
Leave a comment